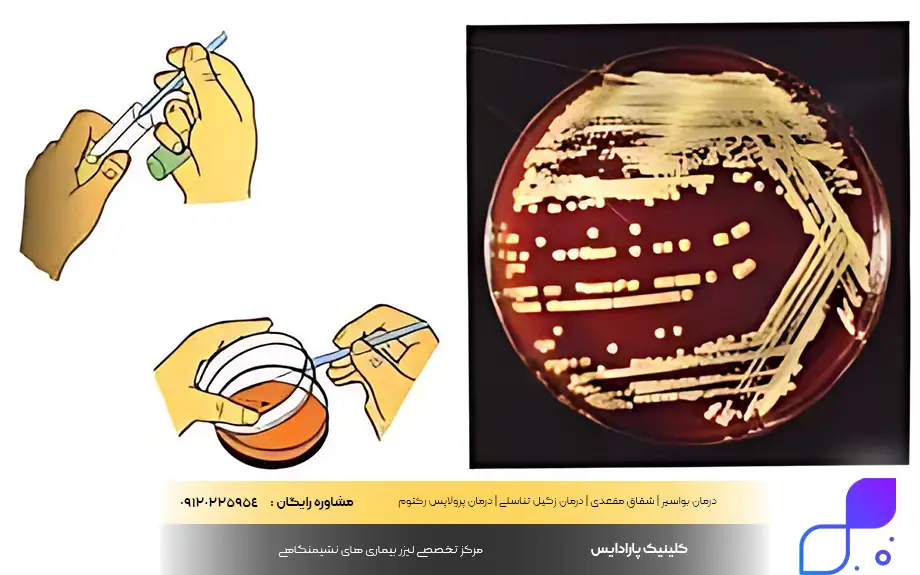
آزمایشات بعد از درمان سوزاک

امروزه با تغییر سبک زندگی و الگوهای رفتاری، آگاهی از سلامت جنسی و عفونتهای آمیزشی (STI) بیش از هر زمان دیگری اهمیت یافته است. بیماری سوزاک که در میان عموم به عنوان یکی از شایعترین عفونتهای باکتریایی شناخته میشود، میتواند هر فردی را که فعالیت جنسی دارد، درگیر کند. سوزاک اگرچه در مراحل اولیه به سادگی قابل مدیریت است، اما ناآگاهی و عدم تشخیص به موقع آن میتواند زمینهساز مشکلات جدی و بلندمدت برای سلامت عمومی بدن و سیستم باروری شود. شناخت دقیق علائم و راههای پیشگیری، اولین خط دفاعی در برابر بیماری مقاربتی سوزاک محسوب میشود.
نکته قابل تامل در مبحث بیماریهای مقاربتی این است که ابتلا به یک عفونت، میتواند خطر ابتلا به سایر بیماریها را نیز افزایش دهد یا نشاندهنده رفتارهای پرخطر باشد. برای مثال، افرادی که درگیر بیماری مقاربتی سوزاک هستند، ممکن است همزمان در معرض خطر ویروس HPV یا زگیل تناسلی نیز باشند. تشخیص افتراقی و درمان تخصصی این ضایعات نیازمند مراجعه به مراکز معتبر است. در همین راستا، کلینیک پارادایس به عنوان یک مرکز تخصصی و پیشرو، با تمرکز بر درمان بیماریهای نشیمنگاهی و ضایعات مقاربتی مانند استفاده از لیزر برای درمان زگیل تناسلی، آماده ارائه خدمات مشاوره و درمان با جدیدترین متدهای روز پزشکی به مراجعین محترم میباشد.
سوزاک چیست
برای پاسخ به این سوال که دقیقا سوزاک چیست، باید به سراغ عامل میکروبی آن برویم. این بیماری یک عفونت مقاربتی است که توسط باکتری خاصی به نام «نایسریا گونوره آ» (Neisseria gonorrhoeae) ایجاد میشود. این باکتری علاقه زیادی به محیطهای گرم و مرطوب بدن دارد و به همین دلیل به سرعت در غشاهای مخاطی مانند مجاری ادراری، دهانه رحم، لولههای فالوپ در زنان و مجرای ادرار در مردان تکثیر میشود. البته دامنه فعالیت این باکتری تنها محدود به اندام تناسلی نیست و میتواند نواحی دیگری مانند دهان، گلو، چشمها و مقعد را نیز آلوده کند.
بسیاری از افراد تصور میکنند که این بیماری متعلق به گذشته است، اما آمارهای پزشکی نشان میدهد که شیوع بیماری سوزاک در جهان همچنان بالاست و سالانه میلیونها نفر به آن مبتلا میشوند. نکته فریبنده در مورد این بیماری این است که در بسیاری از موارد، به خصوص در زنان، ممکن است هیچ علامت اولیه واضحی وجود نداشته باشد و فرد به عنوان یک ناقل خاموش عمل کند. عدم درمان این عفونت باکتریایی میتواند منجر به عوارض جبرانناپذیری همچون بیماری التهابی لگن (PID) و ناباروری شود.
مرکز کنترل و پیشگیری بیماریها (CDC) در مورد بیماری سوزاک چنین بیان می کند:
سوزاک یکی از شایعترین عفونتهای مقاربتی در جهان است و میتواند بدون ایجاد هیچ علامتی پیشرفت کند. تشخیص زودهنگام و درمان مناسب، از بروز عوارض بلندمدت جلوگیری میکند و نقش کلیدی در کنترل چرخه انتقال دارد.
بیماری سوزاک چگونه منتقل می شود
اصلیترین و شایعترین راه انتقال این باکتری، برقراری رابطه جنسی محافظت نشده است. اینکه بدانیم بیماری سوزاک چگونه منتقل می شود به ما کمک میکند تا زنجیره انتقال را قطع کنیم. این باکتری از طریق تماس مستقیم با ترشحات بدن فرد آلوده (مایع منی، ترشحات واژن یا ترشحات حلق) وارد بدن فرد سالم میشود. بنابراین، هرگونه رابطه جنسی شامل واژینال، مقعدی و دهانی میتواند بستری برای انتقال این عفونت باشد. لازم به ذکر است که برای انتقال این بیماری حتماً نیاز به انزال نیست و صرف تماس با ترشحات آلوده کافی است.
علاوه بر روشهای جنسی، یک مسیر انتقال دیگر نیز وجود دارد که مربوط به زمان تولد است. مادر مبتلا میتواند هنگام زایمان طبیعی، عفونت را به نوزاد خود منتقل کند که معمولاً چشمهای نوزاد را درگیر میکند. بسیار مهم است که بدانید بیماری سوزاک از طریق تماسهای معمولی روزمره مانند دست دادن، بغل کردن، استفاده از استخر عمومی یا نشستن روی کاسه توالت فرنگی منتقل نمیشود، زیرا این باکتری نمیتواند مدت زیادی خارج از بدن انسان زنده بماند.
روشهای اصلی انتقال بیماری مقاربتی سوزاک عبارتند از:
- رابطه جنسی واژینال (دخول) بدون استفاده از کاندوم
- رابطه جنسی مقعدی (Anal Sex)
- رابطه جنسی دهانی (Oral Sex) با فرد آلوده (خطر درگیری گلو)
- استفاده مشترک از اسباببازیهای جنسی (Sex Toys) که شسته نشدهاند
- انتقال از مادر آلوده به نوزاد در حین زایمان طبیعی
مراحل بیماری سوزاک
برخلاف برخی بیماریها مانند سیفلیس که مراحل خطکشی شده و مشخصی دارند، مراحل بیماری سوزاک بیشتر بر اساس زمان عفونت و ظهور علائم دستهبندی میشود. مرحله اول، دوره کمون یا نهفتگی نام دارد. پس از ورود باکتری به بدن، معمولاً بین ۲ تا ۱۴ روز طول میکشد تا اولین علائم ظاهر شوند. البته در برخی افراد این دوره ممکن است تا یک ماه هم طول بکشد. در این مرحله، باکتری در حال تکثیر است اما فرد هنوز احساس بیماری نمیکند، با این حال کاملاً قادر به انتقال بیماری به شریک جنسی خود است.
پس از دوره نهفتگی، بیماری وارد فاز حاد یا علامتدار میشود (البته اگر بدون علامت نباشد). اگر در این مرحله درمان صورت نگیرد، عفونت وارد فاز پیشرفته یا عوارض میشود. در این حالت باکتری از موضع اولیه فراتر رفته و به بخشهای بالایی دستگاه تناسلی (مانند رحم یا بیضهها) و یا حتی جریان خون (عفونت گنوکوکی منتشر) حمله میکند. شناخت دقیق مراحل بیماری سوزاک و اقدام در همان فاز اولیه، کلید پیشگیری از آسیبهای دائمی به اندامهای داخلی است.
روند پیشرفت بیماری شامل موارد زیر است:
- دوره کمون (Incubation): فاصله زمانی بین تماس جنسی تا شروع تکثیر باکتری (معمولا ۲ تا ۱۴ روز).
- ظهور علائم (Symptomatic Stage): شروع ترشحات، درد و احساس سوزش در مقعد (در بسیاری از مردان و برخی زنان).
- ناقل خاموش (Asymptomatic): فرد علائمی ندارد اما بیماری در بدن فعال است و منتقل میشود.
- انتشار موضعی: گسترش عفونت به رحم و لولهها در زنان یا اپیدیدیم در مردان.
- عفونت سیستمیک (DGI): ورود باکتری به خون و درگیری مفاصل یا پوست (در صورت عدم درمان طولانیمدت).

دوره نهفتگی سوزاک
یکی از چالشهای اصلی در کنترل بیماریهای آمیزشی، فاصله زمانی بین ورود میکروب به بدن تا لحظه آشکار شدن اولین نشانهها است. دوره نهفتگی سوزاک معمولاً بین ۲ تا ۱۴ روز پس از تماس جنسی مشکوک متغیر است. با این حال، در برخی موارد نادر ممکن است این دوره تا ۳۰ روز نیز به طول انجامد. در این بازه زمانی، باکتریها در حال تکثیر در بافتهای مخاطی بدن هستند، اما فرد هنوز هیچگونه احساس ناراحتی، درد یا ترشح غیرطبیعی ندارد و ممکن است به خیال اینکه سالم است، به روابط جنسی خود ادامه دهد.
آگاهی از مدت زمان دوره نهفتگی سوزاک برای ردیابی شرکای جنسی و جلوگیری از گسترش عفونت بسیار حیاتی است. بسیار مهم است بدانید که نداشتن علامت در این دوره به معنای عدم انتقال بیماری نیست؛ فرد در این مرحله به شدت ناقل است. بنابراین، اگر رابطه جنسی محافظت نشدهای داشتهاید، حتی اگر در روزهای اول احساس سلامت کامل دارید، مراجعه به پزشک و انجام آزمایشهای غربالگری برای اطمینان از عدم ابتلا ضروری است.
بیماری سوزاک در مردان
آناتومی دستگاه تناسلی مردان به گونهای است که معمولاً عفونتهای ادراری و مقاربتی را سریعتر از زنان نشان میدهد. بیماری سوزاک در مردان عمدتاً مجرای ادرار (لوله خروج ادرار) را درگیر میکند، اما میتواند به سایر بخشها نیز سرایت کند. مردان فعال از نظر جنسی، بهویژه در سنین جوانی، بیشتر در معرض این عفونت هستند. خوشبختانه به دلیل ظاهر شدن علائم آزاردهنده مانند سوزش شدید و ترشحات، اکثر مردان زودتر متوجه بیماری شده و برای درمان اقدام میکنند که این امر ریسک عوارض طولانیمدت را کاهش میدهد.
اگر سوزاک مردان به موقع درمان نشود، باکتری میتواند در دستگاه تناسلی پیشروی کرده و لولههای اپیدیدیم (لولههای متصل به بیضه که اسپرم را حمل میکنند) را عفونی کند. این وضعیت میتواند منجر به درد شدید بیضه و در موارد نادیده گرفته شده، باعث ایجاد بافت اسکار و در نهایت ناباروری مردان شود. بنابراین، هرگونه تغییر در روند ادرار یا ظاهر آلت تناسلی باید هشداری جدی برای مراجعه به متخصص اورولوژی یا عفونی تلقی شود.
بیماری سوزاک در زنان
روش های تشخیص بیماری سوزاک در زنان چیست؟ تشخیص در زنان اغلب دشوارتر از مردان است، زیرا بسیاری از زنان مبتلا (حدود ۵۰ درصد یا بیشتر) هیچگونه علامت واضحی را تجربه نمیکنند یا علائم آنها بسیار خفیف و گمراهکننده است. این باکتری در زنان معمولاً دهانه رحم (سرویکس) را هدف قرار میدهد. به دلیل شباهت نشانههای خفیف سوزاک با بیماری های واژن مثل عفونتهای قارچی واژن یا عفونت مثانه، بسیاری از بانوان اقدام به خوددرمانیهای اشتباه میکنند که تنها باعث پیشرفت عفونت اصلی میشود.
خطر اصلی زمانی بروز میکند که بیماری سوزاک در زنان و عوارض آن نادیده گرفته شود. اگر این عفونت درمان نشود، باکتری از دهانه رحم عبور کرده و به رحم و لولههای فالوپ (لولههای رحمی) میرسد. این شرایط میتواند منجر به بیماری التهابی لگن (PID) شود که یکی از دلایل اصلی دردهای مزمن لگنی، حاملگی خارج از رحم و ناباروری در زنان است. از این رو، معاینات دورهای زنان و زایمان برای بانوان فعال جنسی اهمیت دوچندان پیدا میکند.

بیماری سوزاک چه علائمی دارد
شناخت اینکه بیماری سوزاک چه علائمی دارد، اولین قدم برای تشخیص و درمان موفق است. همانطور که اشاره شد، این علائم بسته به محل عفونت (دستگاه تناسلی، مقعد، گلو یا چشم) متفاوت است. به طور کلی، عفونت باکتریایی نایسریا گونوره با ایجاد التهاب شدید در غشاهای مخاطی همراه است که منجر به تولید چرک و درد میشود. این علائم معمولاً صبحها هنگام بیدار شدن از خواب، به دلیل تجمع ترشحات در طول شب، محسوستر هستند.
علاوه بر ناحیه تناسلی، اگر رابطه جنسی مقعدی یا دهانی داشتهاید، باید نسبت به علائم در این نواحی نیز هوشیار باشید. برای مثال، عفونت گلو ممکن است شبیه به یک گلودرد ساده باشد، در حالی که عفونت مقعدی ممکن است با خارش و خونریزی اشتباه گرفته شود. در پاسخ به این پرسش که سوزاک چه علائمی دارد، باید گفت هرگونه ترشح غیرعادی از بدن و سوزش در نواحی مخاطی میتواند زنگ خطری برای این بیماری باشد.
مهمترین علائم سوزاک عبارتند از:
- سوزش و درد هنگام ادرار کردن (دیسوری)
- ترشحات چرکی (غلیظ) به رنگ زرد، سفید یا سبز از واژن یا آلت تناسلی مردانه
- خارش، سوزش و ترشح از مقعد (در صورت رابطه مقعدی)
- گلودرد مداوم و تورم غدد لنفاوی گردن (در صورت رابطه دهانی)
- حساسیت به نور و ترشحات چرکی از چشم (در صورت تماس دست آلوده با چشم)
علائم سوزاک در مردان
مردان معمولاً نخستین تغییرات را در هنگام ادرار کردن احساس میکنند. علائم سوزاک در مردان اغلب با احساس قلقلک یا سوزش خفیف در مجرای ادرار آغاز میشود که به سرعت به دردی شدید و سوزاننده هنگام دفع ادرار تبدیل میگردد. پس از آن، بارزترین نشانه این بیماری یعنی ترشحات عفونی ظاهر میشود. شدت این علائم ممکن است در طول روز متغیر باشد اما معمولاً بدون درمان دارویی (آنتی بیوتیک) برطرف نمیشوند و حتی ممکن است با گذشت زمان بدتر شوند.
در مراحل پیشرفتهتر، عفونت ممکن است بافتهای اطراف را نیز درگیر کند. برخی از بیماران علاوه بر علائم بیماری سوزاک در مردان که در مجرای ادرار رخ میدهد، درد یا تورم در کیسه بیضه را نیز تجربه میکنند که نشاندهنده گسترش عفونت به اپیدیدیم است. توجه به این نشانهها و پرهیز از روابط جنسی تا زمان بهبودی کامل، برای حفظ سلامت خود و شریک جنسی الزامی است.
لیست علائم اختصاصی در مردان شامل:
- احساس درد و سوزش شدید همانند تیغ کشیدن هنگام ادرار
- خروج ترشحات سفید، زرد یا سبز رنگ از نوک آلت تناسلی
- تورم یا قرمزی در دهانه مجرای ادرار
- درد یا تورم در یک یا هر دو بیضه (کمتر شایع ولی خطرناک)
- تکرر ادرار یا احساس فوریت در دفع ادرار

علائم سوزاک در زنان
بسیاری از متخصصان زنان و زایمان، این بیماری را در خانمها یک “عفونت خاموش” مینامند، زیرا در بسیاری از موارد بدون علامت است یا نشانههایی بسیار خفیف دارد. علائم سوزاک در زنان اغلب با عفونتهای باکتریایی واژن یا عفونت مثانه اشتباه گرفته میشود. این اشتباه تشخیصی توسط بیمار، باعث میشود که فرد به جای مراجعه به پزشک، به درمانهای خانگی روی بیاورد که در مورد این باکتری بیاثر هستند. اگر علائم ظاهر شوند، معمولاً شامل تغییرات در ترشحات واژینال (افزایش حجم یا تغییر رنگ به زرد و سبز) و احساس ناراحتی در ناحیه لگن هستند.
خطر اصلی زمانی است که این نشانهها نادیده گرفته شوند. اگر علائم بیماری سوزاک در زنان به موقع تشخیص داده نشود، باکتری میتواند به سمت رحم و لولههای فالوپ حرکت کند. این پیشروی منجر به درد هنگام مقاربت جنسی و درد در ناحیه زیر شکم میشود. همچنین، خونریزیهای غیرطبیعی بین دو قاعدگی (لکه بینی) یکی دیگر از نشانههای هشداردهنده است که نیاز به بررسی فوری پزشکی دارد تا از آسیب به سیستم باروری جلوگیری شود.
نشانههای شایع در زنان عبارتند از:
- افزایش ترشحات واژن (رقیق یا آبکی، گاهی با رنگ زرد یا سبز)
- احساس درد یا سوزش هنگام دفع ادرار
- خونریزی واژینال بین دورههای قاعدگی (لکه بینی)
- خونریزی پس از برقراری رابطه جنسی
- درد در ناحیه شکم یا لگن (نشانه پیشرفت عفونت)
- درد هنگام رابطه جنسی (دیسپارونیا)
روش تشخیص بیماری سوزاک
خوشبختانه با پیشرفت علم پزشکی، شناسایی این عفونت بسیار سریع و دقیق انجام میشود. برای تعیین قطعی ابتلا، پزشک از روش تشخیص بیماری سوزاک که مبتنی بر تستهای آزمایشگاهی است، استفاده میکند. معاینه ظاهری به تنهایی برای تشخیص کافی نیست، زیرا علائم این بیماری با کلامیدیا و سایر عفونتهای مقاربتی شباهت زیادی دارد. پزشک معمولاً در مورد تاریخچه جنسی شما سوالاتی میپرسد و سپس نمونهبرداری لازم را انجام میدهد. صادق بودن با پزشک در این مرحله به تسریع روند درمان کمک شایانی میکند.
در حال حاضر، دقیقترین روش تشخیص بیماری سوزاک، آزمایش ادرار و یا نمونهبرداری (سواپ) از نواحی درگیر است. در آزمایش ادرار، وجود باکتری در مجاری ادراری بررسی میشود. اما اگر احتمال عفونت در گلو یا مقعد وجود داشته باشد، پزشک با استفاده از یک سواپ (شبیه گوشپاککن)، از ترشحات این نواحی نمونهبرداری کرده و به آزمایشگاه میفرستد. در برخی موارد، کشت باکتری نیز انجام میشود تا حساسیت میکروب به آنتیبیوتیکها سنجیده شود و داروی موثر تجویز گردد.
روشهای متداول تشخیص شامل:
- آزمایش ادرار: برای بررسی وجود باکتری در مجرای ادرار.
- تست نمونهبرداری (سواپ): نمونهگیری از دهانه رحم، مجرای ادرار، گلو یا رکتوم (مقعد).
- کشت میکروبی: برای تایید تشخیص و تعیین نوع آنتیبیوتیک موثر.
- تستهای همزمان: بررسی همزمان سایر بیماریهای مقاربتی مانند کلامیدیا و HIV.
سازمان جهانی بهداشت (WHO):
گونههای مقاوم ویروس بیماری مقاربتی سوزاک در حال تبدیل شدن به یک تهدید جدی جهانی هستند. انجام آزمایش دقیق، درمان استاندارد و پرهیز از مصرف خودسرانه آنتیبیوتیکها برای جلوگیری از مقاومت دارویی ضروری است.

سوزاک در رابطه دهانی و مقعدی
بسیاری از افراد به اشتباه تصور میکنند که عفونتهای مقاربتی تنها از طریق رابطه واژینال منتقل میشوند، در حالی که سوزاک در رابطه دهانی و مقعدی نیز به راحتی قابل انتقال است. اگر فردی با دهان خود اندام تناسلی آلوده شریک جنسیاش را تحریک کند (اورال سکس)، باکتری نایسریا گونوره میتواند گلو و لوزههای او را درگیر کند. سوزاک حلقی یا گلو اغلب بدون علامت است، اما گاهی به صورت گلودرد مداوم و تورم غدد لنفاوی گردن بروز میکند که با سرماخوردگی اشتباه گرفته میشود.
در مورد رابطه مقعدی نیز وضعیت مشابه است. سوزاک در رابطه دهانی و مقعدی میتواند باعث ایجاد عفونت در ناحیه رکتوم شود. در این حالت، فرد ممکن است شاهد ترشحات مقعدی، خارش، خونریزی یا درد هنگام اجابت مزاج باشد. نکته مهم این است که استفاده از کاندوم و سد دهانی (Dental Dam) میتواند به طور قابل توجهی خطر انتقال عفونت در این نوع روابط را کاهش دهد. اگر هرگونه رابطه جنسی غیر واژینال داشتهاید، حتماً این موضوع را با پزشک خود در میان بگذارید تا نواحی گلو و مقعد نیز معاینه شوند.
سوزاک درمان دارد
خبر خوب برای بیماران این است که این عفونت باکتریایی کاملاً قابل علاج است. در پاسخ به این سوال که آیا سوزاک درمان دارد، باید گفت بله، اما درمان آن باید تحت نظارت دقیق پزشک و با مصرف آنتیبیوتیکهای خاص انجام شود. امروزه به دلیل استفاده خودسرانه از داروها، گونههای مقاومی از این باکتری به وجود آمدهاند که به “سوپر سوزاک” معروفند؛ به همین دلیل، پزشکان معمولاً از درمانهای دو دارویی (ترکیبی) استفاده میکنند تا اطمینان حاصل کنند که عفونت به طور کامل ریشهکن میشود.
استاندارد طلایی برای درمان سوزاک در حال حاضر، تزریق آمپول آنتیبیوتیک (معمولاً سفتریاکسون) به همراه مصرف قرصهای خوراکی (مانند آزیترومایسین یا داکسیسایکلین) است. بسیار حیاتی است که دوره درمان را کامل کنید، حتی اگر علائم شما پس از چند روز بهبود یافت. قطع زودهنگام دارو باعث میشود باکتریها زنده بمانند و نسبت به دارو مقاوم شوند. همچنین، شریک جنسی شما نیز باید همزمان تحت درمان قرار گیرد تا از ابتلای مجدد (عفونت پینگپنگی) جلوگیری شود.
روشهای درمانی استاندارد عبارتند از:
- تزریق عضلانی آنتیبیوتیک (سفتریاکسون) به عنوان درمان اصلی.
- مصرف آنتیبیوتیک خوراکی (آزیترومایسین یا داکسیسایکلین) برای پوشش کامل عفونت.
- درمان همزمان شریک جنسی (حتی اگر علائمی نداشته باشد).
- پرهیز کامل از رابطه جنسی تا پایان دوره درمان (معمولاً ۷ روز).
- بررسی مجدد پس از درمان (در صورت توصیه پزشک) برای اطمینان از پاکسازی کامل.
سرویس سلامت ملی انگلستان (NHS):
در بیشتر موارد بیماری سوزاک با یک دوره درمان آنتیبیوتیکی استاندارد کاملاً قابل درمان هستند، اما تکمیل دوره درمان، درمان همزمان شریک جنسی و انجام آزمایش پیگیری برای جلوگیری از بازگشت عفونت ضروری است.

درمان سوزاک چند روز طول میکشد
مدت زمان بهبودی بستگی به شدت عفونت و نوع داروی تجویزی دارد، اما معمولاً این سوال پیش میآید که درمان سوزاک چند روز طول میکشد؟ در اکثر موارد، پس از دریافت آنتیبیوتیک تزریقی و شروع داروهای خوراکی، علائم طی ۲۴ تا ۴۸ ساعت کاهش مییابند و فرد احساس بهتری خواهد داشت. با این حال، از بین رفتن کامل باکتریها در بدن و توقف قابلیت انتقال بیماری، حدود ۷ روز زمان میبرد. بنابراین، پزشکان توصیه میکنند حداقل تا یک هفته پس از پایان درمان، از برقراری هرگونه رابطه جنسی خودداری کنید.
مدت زمان تقریبی درمان و بهبودی:
- کاهش علائم اولیه: ۱ تا ۳ روز پس از شروع دارو.
- پاکسازی کامل باکتری از بدن: حدود ۷ روز.
- زمان مجاز برای شروع مجدد رابطه جنسی: ۷ روز پس از پایان کامل داروها و بهبود علائم.
- رفع علائم گلودرد (سوزاک حلقی): ممکن است کمی بیشتر از سایر نواحی طول بکشد (تا یک هفته).
درمان قطعی بیماری سوزاک
بسیاری از افراد پس از ابتلا به عفونتهای مقاربتی، نگران این هستند که آیا راهی برای ریشهکن کردن کامل بیماری وجود دارد یا خیر. باید بدانید که درمان قطعی بیماری سوزاک کاملاً امکانپذیر است، اما این اصطلاح در متون پزشکی معتبر مانند پروتکلهای CDC (مرکز کنترل و پیشگیری بیماریها) و WHO (سازمان بهداشت جهانی) معنای مشخصی دارد. درمان قطعی به معنای استفاده از داروهای خانگی یا گیاهی نیست، بلکه به فرآیندی گفته میشود که طی آن با دریافت دوز استاندارد آنتیبیوتیک تزریقی و خوراکی، باکتری نایسریا گونوره بهطور کامل از بدن حذف شود. پزشکان تأکید دارند که این باکتری به شدت هوشمند است و اگر درمان حتی یک روز زودتر قطع شود، ممکن است عفونت به شکل مقاوم بازگردد.
برای رسیدن به مرحلهای که بتوانیم بگوییم درمان قطعی سوزاک انجام شده است، تنها مصرف دارو کافی نیست. یک اصل طلایی در پزشکی وجود دارد: «درمان شما تا زمانی که شریک جنسیتان درمان نشود، کامل نیست». چرخه انتقال باکتری باید شکسته شود؛ بنابراین پروتکلهای درمانی شامل مجموعهای از اقدامات همزمان برای بیمار و شریک جنسی او، همراه با پیگیریهای آزمایشگاهی دقیق است تا اطمینان حاصل شود که هیچ اثری از باکتری فعال در خون یا مجاری ادراری و تناسلی باقی نمانده است.
اصول و مراحل دستیابی به درمان قطعی:
- دریافت دوز استاندارد و ترکیبی: معمولاً تزریق یک دوز سفتریاکسون به همراه مصرف داکسیسایکلین یا آزیترومایسین (طبق تجویز پزشک).
- تکمیل دوره درمان: مصرف داروها تا آخرین دانه، حتی در صورت رفع کامل علائم ظاهری.
- درمان همزمان پارتنر: درمان شریک یا شرکای جنسی ۶۰ روز اخیر، حتی اگر هیچ علامتی نداشته باشند (برای جلوگیری از عفونت پینگپنگی).
- پرهیز از رابطه جنسی: خودداری کامل از هرگونه تماس جنسی تا ۷ روز پس از پایان درمان و رفع علائم.
- تست مجدد (Test of Cure): انجام آزمایش مجدد (معمولاً ۳ ماه بعد) برای اطمینان از عدم ابتلای مجدد.
درمان سریع سوزاک زنان
ساختار آناتومیک بدن زنان بهگونهای است که عفونتها میتوانند به سرعت و در سکوت پیشرفت کنند؛ به همین دلیل درمان سریع سوزاک زنان از اولویت بسیار بالایی برخوردار است. برخلاف مردان که معمولاً با سوزش ادرار متوجه بیماری میشوند، زنان اغلب «بدون علامت» هستند یا علائمی شبیه به یک عفونت ساده قارچی دارند. این بیعلامتی خطرناک است زیرا باکتری فرصت پیدا میکند بدون مزاحمت، از دهانه رحم عبور کرده و به سمت رحم و لولههای فالوپ حرکت کند. شروع سریع آنتیبیوتیک مناسب، تنها راهی است که میتواند این پیشروی را متوقف کند و جلوی آسیبهای بافتی را بگیرد.
اگر درمان سریع بیماری سوزاک در زنان به تعویق بیفتد، عواقب آن میتواند تمام آینده باروری فرد را تحت تأثیر قرار دهد. تأخیر در مراجعه به پزشک، خطر ابتلا به بیماری التهابی لگن (PID) را به شدت افزایش میدهد که یکی از دلایل اصلی دردهای مزمن لگنی و ناباروری ناشی از انسداد لولههای رحمی است. بنابراین، هرگونه ترشح غیرعادی واژینال، خونریزی بین دورههای قاعدگی یا درد هنگام نزدیکی باید به عنوان یک زنگ خطر جدی تلقی شود و بلافاصله پروسه درمان دارویی آغاز گردد؛ در طول این مدت نیز داشتن رابطه جنسی ممنوع است تا التهاب بافتها تشدید نشود.
روشها و نکات کلیدی برای درمان فوری در زنان:
- شروع فوری رژیم آنتیبیوتیکی: تجویز دوزهای بالا و ترکیبی آنتیبیوتیک بلافاصله پس از تشخیص احتمالی.
- غربالگری سریع در بارداری: انجام تست در اولین ویزیت بارداری برای جلوگیری از انتقال به جنین و درمان اورژانسی.
- توقف کامل فعالیت جنسی: برای جلوگیری از تحریک دهانه رحم و انتقال مجدد عفونت تا بهبودی کامل.
- بررسی همزمان سایر عفونتها: درمان همزمان کلامیدیا (که اغلب همراه بیماری مقاربتی سوزاک است) برای سرعت بخشیدن به روند بهبودی.

قویترین انتی بیوتیک برای درمان سوزاک
امروزه با پدیدهای به نام «سوزاک مقاوم به درمان» یا «سوپر سوزاک» مواجه هستیم که باعث شده پزشکان در تجویز قویترین انتی بیوتیک برای درمان سوزاک بسیار حساس و دقیق عمل کنند. در گذشته پنیسیلین داروی موثری بود، اما اکنون این باکتری نسبت به بسیاری از داروهای قدیمی مقاوم شده است. در حال حاضر، پروتکلهای جهانی (مانند CDC) توصیه میکنند که دیگر از تکدرمانی استفاده نشود. قویترین رویکرد درمانی، استفاده از «درمان دوگانه» (Dual Therapy) است که شامل یک آنتیبیوتیک تزریقی بسیار قوی برای حمله سیستمیک به باکتری و یک آنتیبیوتیک خوراکی برای پاکسازی کامل عفونتهای همزمان مانند کلامیدیا میباشد.
انتخاب نوع دارو برای بیماری سوزاک باید حتماً توسط متخصص عفونی یا اورولوژیست انجام شود، زیرا مصرف خودسرانه آنتیبیوتیکها تنها باعث قویتر شدن باکتری میشود. پزشکان معمولاً ترکیبی از سفالوسپورینهای نسل سوم را به عنوان خط اول درمان انتخاب میکنند. این داروها با مکانیسم اثر خاص خود، دیواره سلولی باکتری را تخریب کرده و تکثیر آن را متوقف میکنند. توجه داشته باشید که دوز این داروها بر اساس وزن، شدت عفونت و محل درگیری (گلو، مقعد یا دستگاه تناسلی) متفاوت است.
لیست موثرترین آنتیبیوتیک و دارو برای بیماری سوزاک:
- سفتریاکسون (Ceftriaxone): قویترین آمپول تزریقی (عضلانی) و خط اول درمان استاندارد جهانی.
- آزیترومایسین (Azithromycin): آنتیبیوتیک خوراکی قوی که معمولاً همزمان با تزریق تجویز میشود.
- داکسیسایکلین (Doxycycline): جایگزین خوراکی که باید دو بار در روز و به مدت یک هفته مصرف شود.
- سفیکسیم (Cefixime): تنها در صورتی تجویز میشود که دسترسی به سفتریاکسون تزریقی امکانپذیر نباشد (قدرت کمتری دارد).
- جنتامایسین (Gentamicin): در موارد خاص و برای افرادی که به سفالوسپورینها آلرژی دارند استفاده میشود.

درمان خانگی بیماری سوزاک
بسیار مهم است که بدانید، هیچ درمان خانگی بیماری سوزاک وجود ندارد که بتواند جایگزین آنتیبیوتیک شود. باکتری نایسریا گونوره یک ارگانیسم سرسخت است و با گیاهان دارویی، سرکه، سیر یا عسل از بین نمیرود. تکیه بر روشهای سنتی به عنوان درمان اصلی، خطرناکترین اشتباهی است که میتواند منجر به پیشرفت عفونت به سمت خون و ناباروری دائمی شود. با این حال، درمانهای خانگی میتوانند به عنوان یک روش مکمل و حمایتی در کنار داروهای تجویزی پزشک، به تسکین علائم آزاردهنده و تقویت سیستم ایمنی بدن کمک کنند.
هدف از انجام اقدامات مربوط به درمان بیماری سوزاک در خانه، سرعت بخشیدن به روند بهبودی و کاهش عوارض جانبی آنتیبیوتیکها است. برای مثال، مصرف آنتیبیوتیکهای قوی ممکن است فلور طبیعی روده و واژن را برهم بزند و زمینه را برای عفونتهای قارچی فراهم کند؛ بنابراین تمرکز بر تغذیه و سبک زندگی در دوره درمان اهمیت دارد. به هیچ عنوان سعی نکنید با شستشوهای تهاجمی داخل واژن یا مجاری ادرار، عفونت را خارج کنید، زیرا این کار تنها باعث هل دادن باکتری به نقاط بالاتر دستگاه تناسلی میشود.
اقدامات حمایتی و مکمل در خانه (نه جایگزین دارو):
- مصرف پروبیوتیکها: خوردن ماست یا مکملهای پروبیوتیک برای بازسازی باکتریهای مفید روده پس از مصرف آنتیبیوتیک.
- هیدراتاسیون قوی: نوشیدن آب فراوان برای کمک به دفع باکتریها از مجاری ادراری و رقیق شدن ادرار (کاهش سوزش).
- اجتناب از محرکها: پرهیز از غذاهای تند، الکل و کافئین که التهاب مثانه را تشدید میکنند.
- رعایت بهداشت فردی: شستشوی ناحیه تناسلی با آب ولرم و شویندههای ملایم (بدون عطر) و خشک نگه داشتن ناحیه.
- کمپرس سرد: استفاده از کمپرس یخ (با واسطه پارچه) برای کاهش تورم و درد در ناحیه تناسلی یا مفاصل درگیر.
آزمایشات بعد از درمان سوزاک
پس از پایان دوره مصرف داروها، بسیاری از بیماران تصور میکنند که کار تمام شده است، اما از نظر علمی انجام آزمایشات بعد از درمان سوزاک برای تایید ریشهکنی باکتری ضروری است. گاهی اوقات علائم ظاهری از بین میروند، اما باکتریها به تعداد کم در مجاری ادراری یا گلو مخفی میمانند و فرد همچنان ناقل بیماری باقی میماند. این آزمایشها که اصطلاحاً “Test of Cure” نامیده میشوند، به پزشک اطمینان میدهند که روش درمانی موثر بوده و مقاومت آنتیبیوتیکی رخ نداده است. همچنین با توجه به اینکه احتمال ابتلای مجدد در ماههای اول بالاست، غربالگری مجدد بخشی حیاتی از پروسه درمان محسوب میشود.
زمانبندی انجام آزمایشات بعد از درمان سوزاک بسیار مهم است. اگر بلافاصله پس از آخرین قرص آزمایش دهید، ممکن است نتیجه به اشتباه مثبت شود (وجود لاشه باکتریهای مرده). معمولاً توصیه میشود آزمایش کشت یا NAAT حدود ۷ تا ۱۴ روز بعد از درمان برای موارد خاص و یا غربالگری مجدد ۳ ماه بعد برای همه بیماران انجام شود. این آزمایشها نه تنها پاک شدن بدن از باکتری گنوکوک را بررسی میکنند، بلکه فرصتی برای چک کردن سایر بیماریهای مقاربتی است که ممکن است در دوره نهفتگی بوده باشند.
لیست آزمایشهای ضروری پس از درمان:
- تست NAAT (تست تقویت اسید نوکلئیک): دقیقترین تست برای تشخیص وجود ژن باکتری در ادرار یا ترشحات.
- کشت باکتری (Culture): نمونهبرداری مجدد از گلو، مقعد یا دهانه رحم (بسیار مهم در موارد مقاوم به درمان).
- آزمایش ادرار مجدد: برای بررسی وجود گلبولهای سفید و عفونت باقیمانده.
- پنل کامل STI: آزمایش همزمان برای سیفلیس، HIV و کلامیدیا (چون ابتلا به سوزاک ریسک این موارد را بالا میبرد).
عوارض بیماری سوزاک
نادیده گرفتن علائم یا درمان ناقص این عفونت میتواند منجر به بروز عوارض بیماری سوزاک شود که گاهی تا پایان عمر همراه فرد باقی میماند. باکتری گنوکوک اگر مهار نشود، تمایل دارد از طریق جریان خون به سایر نقاط بدن سفر کند. این یعنی بیماری که با یک ترشح ساده شروع شده، میتواند به قلب، مفاصل و حتی مغز آسیب برساند. علاوه بر مشکلات جسمی، عوارض روانی ناشی از ناباروری یا دردهای مزمن نیز بخشی از تبعات عدم درمان به موقع این بیماری است که کیفیت زندگی فرد را به شدت تحت شعاع قرار میدهد.
در میان تمام پیامدها، برخی موارد در دسته عوارض خطرناک بیماری مقاربتی سوزاک طبقهبندی میشوند که نیاز به بستری فوری در بیمارستان دارند. یکی از خطرناکترین آنها، عفونت گنوکوکی منتشر (DGI) است که باعث تب بالا، ضایعات پوستی دردناک و آرتریت سپتیک (عفونت مفاصل) میشود. همچنین در زنان، چسبندگی لولههای رحمی و حاملگی خارج از رحم (Ectopic Pregnancy) میتواند جان مادر را تهدید کند. شناخت این عوارض به ما یادآوری میکند که سوزاک یک بیماری ساده نیست و باید جدی گرفته شود.
جدول عوارض و تأثیرات طولانیمدت:
| نوع عارضه | جنسیت درگیر | تاثیرات و خطرات بر بدن |
| بیماری التهابی لگن (PID) | زنان | ایجاد بافت اسکار در لولههای فالوپ، دردهای مزمن شکمی، آبسه تخمدان. |
| ناباروری (Infertility) | مردان و زنان | انسداد لولههای رحمی در زنان و عفونت اپیدیدیم (اپیدیدیمیت) در مردان. |
| عفونت منتشر (DGI) | هر دو جنس | ورود باکتری به خون، درد و تورم شدید مفاصل (آرتریت)، بثورات پوستی چرکی. |
| حاملگی خارج از رحم | زنان | لانه گزینی جنین در لولههای آسیبدیده رحمی که تهدیدکننده حیات است. |
| افزایش خطر HIV | هر دو جنس | التهاب ناشی از سوزاک، ورود ویروس ایدز به بدن را آسانتر میکند. |
| نابینایی نوزاد | نوزادان | انتقال عفونت از مادر هنگام زایمان که میتواند منجر به کوری دائمی نوزاد شود. |
پیشگیری از بیماری سوزاک
در دنیای پزشکی همیشه گفته میشود که پیشگیری بر درمان مقدم است و این اصل در مورد عفونتهای مقاربتی صدق میکند. برای پیشگیری از بیماری سوزاک، آگاهی و تغییر رفتار جنسی مهمترین سلاح شماست. از آنجایی که این بیماری واکسن ندارد، تنها راه ایمن ماندن، ایجاد موانع فیزیکی و شیمیایی در برابر انتقال باکتری است. استفاده صحیح و مداوم از کاندوم لاتکس در تمامی مراحل رابطه جنسی (نه فقط در لحظه انزال)، خطر انتقال باکتری نایسریا گونوره را به شدت کاهش میدهد. همچنین، صحبت شفاف با شریک جنسی درباره تاریخچه سلامت و انجام آزمایشهای قبل از شروع رابطه، نشاندهنده مسئولیتپذیری و بلوغ فکری است.
علاوه بر استفاده از محافظ، محدود کردن تعداد شرکای جنسی نیز نقش بسزایی در کاهش ریسک ابتلا دارد. هرچه دایره روابط گستردهتر باشد، احتمال برخورد با فرد آلوده و جلوگیری از بیماری سوزاک دشوارتر میشود. برای افرادی که فعالیت جنسی بالایی دارند، غربالگری منظم (هر ۳ تا ۶ ماه) توصیه میشود تا در صورت ابتلا، زنجیره انتقال سریعاً قطع گردد. به یاد داشته باشید که دوش واژینال یا ادرار کردن بعد از رابطه جنسی، اگرچه کمککننده هستند، اما به هیچ وجه روشهای مطمئنی برای جلوگیری از ورود این باکتری نیستند.
روشهای کلیدی و موثر پیشگیری:
- استفاده از کاندوم: استفاده از کاندوم مردانه یا زنانه در هر نوع رابطه (واژینال، مقعدی و دهانی).
- پایبندی به تکهمسری (Monogamy): داشتن رابطه جنسی تنها با یک شریک مطمئن و سالم.
- غربالگری منظم (Screening): انجام آزمایشهای دورهای STI برای خود و شریک جنسی.
- استفاده از سد دهانی (Dental Dam): جلوگیری از تماس مستقیم دهان با نواحی تناسلی یا مقعد.
- پرهیز از رابطه جنسی در صورت مشاهده علائم: خودداری از نزدیکی در صورت دیدن هرگونه زخم در مقعد، ترشح یا بثورات در پارتنر.
نتیجهگیری
بیماری سوزاک به عنوان یک بیماری عفونی باکتریایی، چالشی جدی در سلامت عمومی محسوب میشود که مرزهای جنسیتی و سنی را درمینوردد. نادیده گرفتن علائم یا شرم از مراجعه به پزشک، تنها به باکتری فرصت میدهد تا ریشههای خود را در سیستم باروری و خونی بدن محکمتر کند و عوارضی نظیر ناباروری و دردهای مزمن لگنی را رقم بزند. آگاهی از روشهای انتقال، پایبندی به اصول پیشگیری و اقدام سریع برای درمان دارویی، مثلث طلایی برای حفظ سلامت جنسی است. فراموش نکنید که سلامت شریک جنسی شما، تضمینکننده سلامت شماست و درمان باید همواره دوطرفه باشد.
در موارد پیشرفته، عفونتهای مقاربتی درمان نشده مانند سوزاک رکتال (مقعدی) میتوانند زمینه را برای ایجاد عفونتهای بافتی عمیق و حتی آبسه فراهم کنند. آبسههای ناحیه نشیمنگاهی تودههای چرکی و دردناکی هستند که نیاز به تخلیه فوری دارند. در همین راستا، کلینیک پارادایس با بهرهگیری از تیم پزشکی مجرب و تجهیزات لیزری پیشرفته، به عنوان مرکزی تخصصی در زمینه درمان بیماریهای نشیمنگاهی از جمله درمان آبسه مقعد و زگیلهای تناسلی شناخته میشود. اگر با عوارض پیچیده عفونتهای مقاربتی یا ضایعات ناحیه مقعد مواجه هستید، مراجعه به این مرکز میتواند مسیر بهبودی شما را با کمترین درد و عارضه هموار سازد.
سوالات متداول (FAQ)
آیا بیماری سوزاک پس از یک بار درمان، ایمنی دائمی ایجاد میکند؟
خیر. درمان موفقیتآمیز بیماری سوزاک به این معنا نیست که شما در برابر بیماری ایمن شدهاید. بدن انسان در برابر سوزاک آنتیبادی محافظ تولید نمیکند و در صورت تماس جنسی مجدد با فرد آلوده، قطعاً دوباره مبتلا خواهید شد.
اگر باردار باشم، سوزاک چه خطری برای نوزادم دارد؟
اگر سوزاک در دوران بارداری درمان نشود، میتواند هنگام زایمان طبیعی به نوزاد منتقل شود. این امر میتواند باعث عفونت شدید چشم (کوری نوزاد)، عفونت مفاصل و یا عفونتهای خونی تهدیدکننده حیات در نوزاد شود.
آیا بیماری سوزاک از طریق بوسیدن یا ظروف مشترک منتقل میشود؟
خیر. باکتری سوزاک خارج از بدن انسان بسیار آسیبپذیر است و سریع میمیرد. این بیماری از طریق بوسیدن معمولی، بغل کردن، استخر، توالت فرنگی یا استفاده از ظروف مشترک منتقل نمیشود.
آیا ممکن است همزمان به بیماری مقاربتی سوزاک و سیفلیس یا ایدز مبتلا باشم؟
بله. داشتن یک عفونت مقاربتی (STI) فعال مانند سوزاک، به دلیل ایجاد التهاب و زخمهای میکروسکوپی، خطر دریافت و انتقال سایر ویروسها مانند HIV را به میزان قابل توجهی افزایش میدهد.
منابع:
https://www.who.int/news-room/fact-sheets/detail/sexually-transmitted-infections-stis
https://www.nhs.uk/conditions/gonorrhoea
